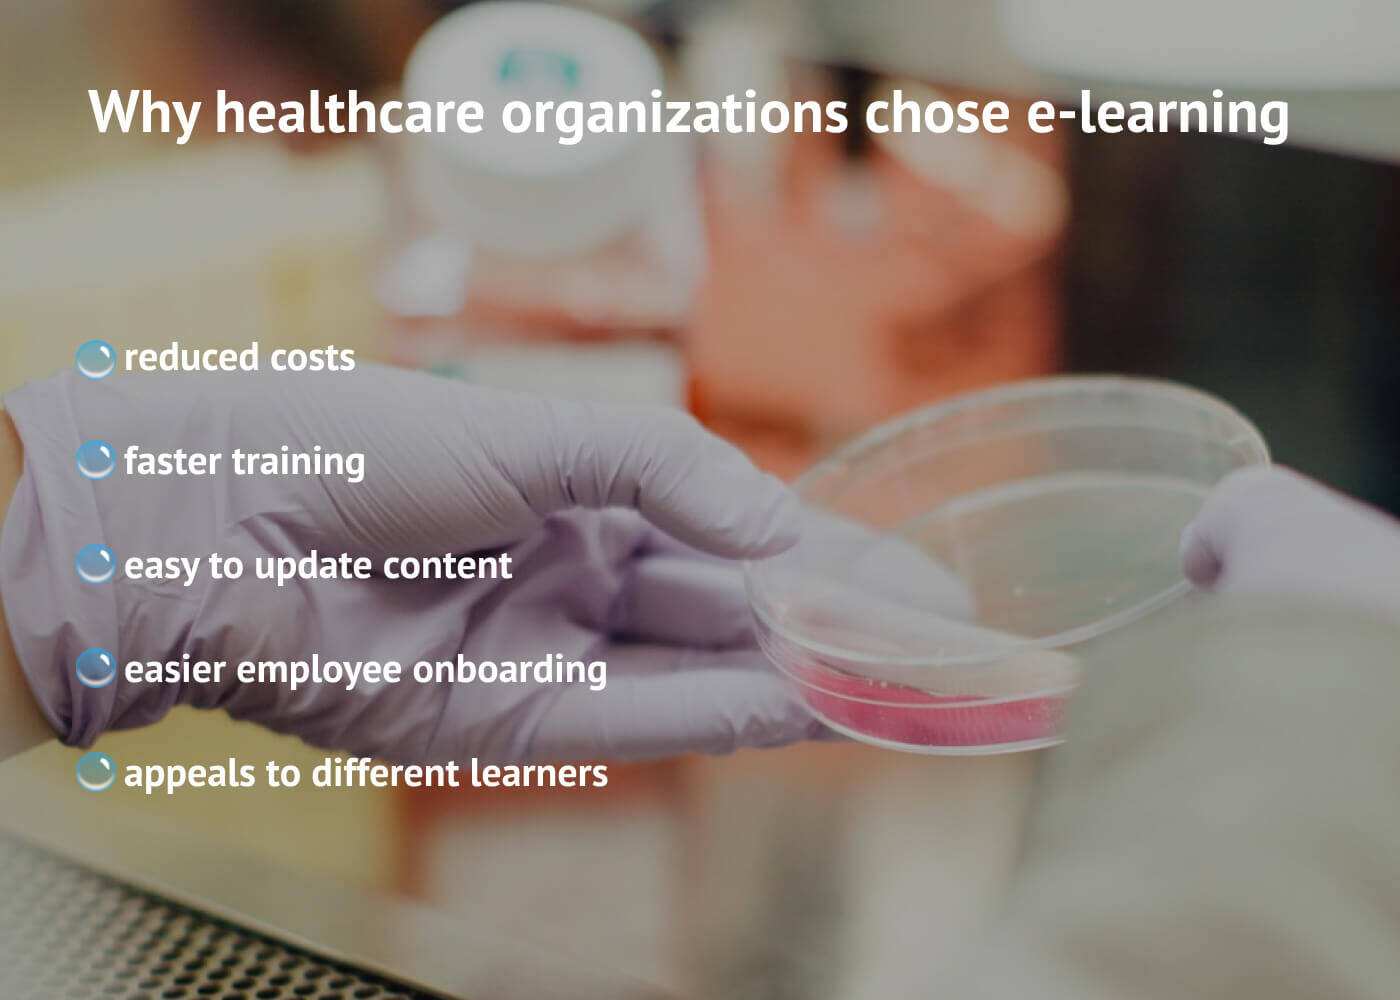
Custom E-learning Apps for Healthcare: Types, Benefits, Development Costs pic 1 1 - Custom E-learning Apps for Healthcare: Types, Benefits, Development Costs

In this series of articles, we’re examining how e-learning software solutions are applied across various industries and what problems they typically solve. Today we’ll discuss the types of e-learning solutions popular in the healthcare industry and what benefits they offer.
E-learning is helpful when traditional education is costly and time-consuming, especially when healthcare workers need to learn new skills quickly. For example, in 2020, medical students have been called upon to volunteer in hospitals before they even graduated, in response to the COVID-19 pandemic. They had no time for extra education, so e-learning came in handy.
There are other situations when healthcare facilities have chosen e-learning over traditional learning because of its indisputable advantages.
Why use LMS in healthcare instead of traditional education?
Here are some benefits that online education provides to healthcare organizations.
Why healthcare organizations chose e-learning
Reduced costs.
With online training, organizations spend less on learning delivery: there is no need for an instructor to come on-site to deliver a course, and no need for printed materials. Rather than going from place to place to conduct training, a tutor can create a course once and students can access the online educational materials whenever they’re comfortable doing so. It is also easier to teach large groups of students at once, using online videoconferencing and similar tools.
Faster training.
An online education course can be built in a manner that allows for efficient use of every minute of online learning time. A student who is already familiar with some part of the course can skip it and move forward to new information.
Easy to update and add new course content.
The healthcare industry demands constant changes and upgrades as new treatments are introduced, new diseases discovered, new compliance procedures developed, and so on. Doctors, medical students, nurses and others need to stay on top of all this information. The easiest way to keep them updated on the latest information is through online medical courses, which are cheaper and easier to conduct than traditional education.
Easier employee onboarding.
E-learning is used for more than training medical staff in important skills. Online education platforms are also a good fit when new medical staff are coming on the job. A cloud-based educational platform allows a new employee to grasp all company policies and training materials on the go.
Appeals to different types of learners.
It is clear that different people learn differently; some are better listeners, others prefer to read and take notes. Medical e-learning platforms can provide all groups of learners with the type of content they most prefer, thus enhancing the overall effectiveness of the training.
Want a healthcare e-learning solution for your business?
Our highly skilled professionals are ready to build your project. Come in with a specification or just share your ideas – we are happy to help with any type of medical software.
Julia Tuskal
Head of Sales
at Hymux Technologies
When healthcare organizations recognize the need for an e-learning solution, they usually start by exploring the various types available to the medical community, which serve different needs. Let’s take a look at some of the most popular ones.
Types of e-learning apps for the healthcare industry
In healthcare, these are the five most popular types of online education solutions:
- Employee training platform
- Student education VR platform
- 3D imaging and MOA
- Webinar platforms
- Localization and cultural sensitivity education
We’ll take a look at these and sort out the following for each type:
- What features it must have
- What team composition is needed to develop it
- How much it will cost to develop

What types of online educaton solutions are popular in healthcare
LMS for employee training
The medical field evolves rapidly, and if healthcare professionals fail to keep up with new health management techniques and medical best practices, they will fail to deliver the best care. This could cost someone’s life and result in lawsuits and major costs for the medical facility.
To remain effective and compliant with current standards, healthcare organizations need to develop educational programming and promote e-learning as the best source for on-the-go education. The most popular platform for employee training and education delivery is a Learning Management System.
Features of LMS
A Learning Management System for healthcare is more often a web solution with cloud-based data exchange. A good LMS platform offers features such as:
- a course catalog,
- learning path management,
- student performance tracking, and
- reporting.
It lets moderators know what educational modules a student has passed, provides a measurement of their performance, and describes what they still want or need to learn, which is extremely important for healthcare professionals dealing with new medical information.
Time & Cost of LMS development
The typical team for a custom LMS development will include:
- developers,
- testers,
- a project manager,
- UX/UI designers,
- a business analyst, and
- a content creator for the course — a healthcare professional capable of teaching other healthcare workers.
Knowing the average hourly rate paid to members of the team — we will take $35 in these examples — and how much time it will take to develop particular features provides an estimate of how much it will cost to build an LMS solution.

Employee training solutions in healthcare
Building an LMS solution will take around 2000 hours, depending on the complexity of features. Note that this estimate doesn’t include the cost of developing the educational content; that varies too much to estimate. Outside of that cost, however, you will need to spend around $70,000.
VR training platforms for medical simulation
VR is the most popular feature for boosting students’ attention while studying. It enhances nearly every learning activity by providing immersive experiences that are easier to grasp than traditional education.
VR in e-learning helps students develop new medical skills, prepare for dealing with trauma cases and emergencies, train in surgical skills, and so on — everything in virtual reality, with no chance of causing accidental harm to a real person.
VR training platform features
The most likely scenario is to either develop a separate mobile VR education app or to build such an application as a companion app to a full-functioned e-learning platform. If you pick the first approach, you will only need to develop a mobile app with standard mobile features: on-the-go access to learning materials, user-friendly UI, compact course catalog, offline access to preloaded course materials; plus, of course, a VR module for translating immersive experiences.
Time & Cost of building a VR e-learning solution
The most effective team will include:
- project manager,
- mobile developer,
- business analyst,
- VR developer,
- tester,
- designer and
- 3D content designer,
- DevOps.
Building only a mobile VR education app will take around 1500 hours and cost around $47,000. If we’re talking about developing a full-fledged platform for online education with a companion mobile VR app, then it will take around 4000 hours and cost around $140,000.

Mobile Virtual Reality platforms for education in healthcare
3D imaging and MOA platforms
With the help of 3D imaging, medical practitioners can visualize internal organs through digital means. Now there is no need to use donated cadavers to practice working with organs, or just to determine their positioning and how they function. Both students and experienced doctors use 3D imaging to practice and study, cheaply and conveniently.
The radiology department is dependent on 3D imaging as well — computing infrastructure is redesigned yearly to produce clearer 3D images with higher resolution.
Another type of 3D imaging is a Mechanism of Action (MOA) visualization solution. MOA educational solutions help visualize how different processes happen inside the human body: how neural connections work inside the brain, how cellular and extracellular molecular interactions work.
Features in 3D imaging and MOA platforms
The fundamentals of such a platform most likely consist of a traditional full-function e-learning platform with:
- standard login and registration,
- course catalog,
- user profile,
- testing module, and other features.
Time & Cost of building 3D imaging and MOA platforms
To build a 3D imaging and Mechanism of Action platform, you will need a project manager, a business analyst, a VR developer, a tester, a designer and a 3D content designer, and a DevOps.

3D imaging and MOA solutions in healthcare education
Building a custom e-learning platform with 3D imaging and MOA modules will take more than 2500 hours and will cost more than $90,000. The cost and total time spent depend on the complexity of 3D imaging and MOA module features — will they provide simple imaging or complex, multi-layer views for radiological purposes?
Webinar platforms
Webinar platforms are simple yet efficient education delivery tools. They are also the most popular of all e-learning platforms, and the healthcare industry uses uses video streaming to deliver knowledge at a lower cost of time and money.
Webinars are extremely useful when it is not possible to gather all students in one place quickly, or when the tutor can’t come physically to conduct a lesson, or when it’s important to spread information faster. For example, when the COVID-19 pandemic struck, webinars became the most popular means of communication and content delivery globally — and not only for the healthcare industry.
Webinar platform features
Important features include:
- compatibility with various browsers,
- multiple-attender handling,
- user-friendly dashboards,
- screen sharing,
- fast live chat,
- automatic video recording, and so on.
Time & Cost of building a medical webinar platform
The best team will consist of:
- a project manager,
- a group of developers,
- a mobile developer if you want a mobile application as well,
- a business analyst,
- a QA,
- a DevOps, and
- a UX/UI designer.
Building a custom webinar platform with such a team will take around 2000 hours or less, and will cost $70,000 or less.

Webinar platforms for healthcare education
Localization and cultural sensitivity education
One goal in the healthcare field today is to provide localization and culturally sensitive learning. This type of education is extremely important, for example, for medical personnel who will be working in a country with a different culture and social mores than they are accustomed to.
Another facet of this type of e-learning may be to offer several class protocols to cope with restrictions and sensitivities in conservative cultures, for instance veiled women.
Features of a cultural sensitivity education platform
This type of education can be delivered through custom content delivery solutions, either webinar platforms, desktop software, or mobile apps. The choice depends on the type of educational content — whether it be live courses presented by tutors, text content, or prerecorded videos.
What team will be needed to build such software?
The largest team you will need would consist of:
- a project manager,
- a group of developers,
- a mobile developer if we’re talking about a mobile app,
- a business analyst,
- a QA,
- a DevOps,
- a UX/UI designer.

Localization and cultural sensitivity education for healthcare
The time spent on such a solution will range somewhere around 1500-2000 hours, and the cost is $45,000 – $70,000.
Our experience
At Hymux Technologies, we have developed a set of e-learning platforms. Here are the details of some of them:
E-learning and Performance Tracking System
We built a cloud-based SaaS LMS for a number of users from multiple industries. The system combines learning management system features with performance management.
Once these two facets of LMS were brought together, the system got a fresh coat of paint:
- Line managers can now see employee-related KPIs via thoughtfully designed dashboards.
- Based on this information, they can identify performance gaps and build competency models.
- These models go to the employee training department, which then develops an online course to eliminate the employees’ weak points.
- Once an employee finishes training, the custom learning management system analyzes the results, builds a report and sends it to the manager and training department.
The system then can be enhanced based on feedback from all the parties.
This is an extremely handy solution for large companies that have hundreds of employees who need to gain similar knowledge and skills.
Video Course for Equipment Diagnosis
This video course features more than 30 interactive activities that educate users on how to work with a system for automobile diagnosis.
The solution boasts rich interactive features that allow users to monitor and supervise the educational process.
When students complete a particular tutorial, they can take an exam. The system processes the answers to further evaluate how the student performed.
The bottom line
What type of e-learning solution the healthcare sector requires always depends on the type of educational services the industry or a particular facility most needs right now: whether it is important to get students prepared to battle a new virus, or to prepare doctors for the cultural differences in the country they are going to work in. However, e-learning is a top choice for ongoing healthcare education thanks to:
- Reduced costs
- Faster training
- Easier content updates
- Easier onboarding process
- A variety of approaches to different types of students
When considering developing a medical e-learning solution, note that these are the types of software most in demand right now:
- Employee training software
- VR platforms for student engagement
- 3D imaging and MOA platforms
- Webinar platforms
- Cultural sensitivity education platforms
Front-end Development Team Lead at Hymux Technologies
An experienced and inquisitive developer, a true expert in front-end development. Primarily interested in Angular and Vue, ready to share his experience with trainees and readers.
FAQ
What does LMS mean?
What is the main function of LMS?
What are examples of LMS?
What are the benefits of LMS?
What are some features of an LMS?
Related Posts
View All
We are open to seeing your business needs and determining the best solution. Complete this form, and receive a free personalized proposal from your dedicated manager.
Sergei Vardomatski
Founder





